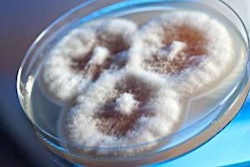
Fumonisins are hepatotoxic to all animal species and have a number of additional effects that reduce the performance of poultry when present in feed.

Phytases entered commercial use in the early 1990s and are now widely included in monogastric diets. However, phosphorus (P) replacement values determined by controlled trials are not always replicated in the field, and feed manufacturers have become wary of recommendations, often reducing the P matrix value applied to the phytase.
The phytase matrix is the nutrient savings made on the inclusion of the enzyme in the diet and is responsible for the feed cost savings over and above the cost of the enzyme.
With rising feed costs, decisions made on the phytase P matrix and the P requirements of the animal are now under intense scrutiny. Safety margins in dietary P are under pressure, challenging the matrices of all phytases. Feed producers should consider how matrices are derived, taking into account safety margins, to evaluate product efficacy.
Problems with determining the matrix
If phytase is optimally applied, it must restore the growth rate and bone ash to the levels that would be achieved before the matrix P value inorganic phosphate was removed.
There are three methods employed to determine how effective a phytase is at replacing inorganic P:
- Growth studies
- Bone ash studies
- Digestibility studies
A key issue is that there are significant variations between studies in the matrices of a given phytase, and a universal matrix value is difficult to justify. The question is: How much of a safety margin is placed on the phytase P matrix in the first place to compensate for the variation noted in the literature?
The simple answer is that matrices are commonly estimated as the simple average of trials for given products with no significant safety margin. This means that in half of any trials where the diet is formulated with this average matrix value, the phytase would underperform in terms of expected P release.
An example of this approach is given in Figure 1, where the estimated non-phytate P (nPP) value for a given dose of a particular phytase from 11 different studies is compiled in one graph.
The dose relationship shown in Figure 1 is log/linear and a matrix value assigned for 1,000 U/kg of this phytase was 0.15 percent nPP. While this is correct on average, half of the time the enzyme will deliver less P than expected and half more. Provided there is enough safety margin in the P content of the diet or the requirements of the animal, even when the enzyme delivers less than expected, production problems will not be detected.
Testing the matrix
A major problem is that trials conducted to verify matrix values are incorrectly carried out.
The available phosphorus (avP) content of the positive control (PC) diet represented in Figure 2 supplies avP at the requirement level. The negative control (NC) diet, with 0.1 percent less avP, would then be expected to give lower performance. In such a situation, if a phytase with a matrix value of 0.10 percent is added to the NC, it should restore the performance level to that of the PC.
In many trials, the positive control often delivers avP at above the animal's requirements. Consequently, the results in Figure 3 could easily arise, where the calculated deficiency is substantially greater than the actual deficiency endured by the animal. The application of a phytase to NC1, which is expected to release 0.20 percent avP but only released 0.10 percent, will succeed in restoring performance while not meeting matrix expectations. If trials are conducted without appropriate inorganic P supplemented diets to demonstrate where the true requirement lies, then such "proof" should be questioned.
The ideal test of a phytase matrix would employ a NC diet which is severely P deficient, supplemented with graded levels of inorganic P or phytase such that the highest dose of phytase used does not result in performance that is equal to that of the PC.
If performance of the highest dose of phytase is equal to that of the PC, it is not clear whether that particular dose just managed to achieve PC performance, or whether substantially less phytase could have achieved the same result. Any dosage of phytase which equals PC performance should be removed from the data set. Given such a test, the matrix can be justified under the circumstances of the trial.
How to avoid a matrix problem
A number of factors influencing animal response to phytase addition have been identified, including phytase, phytate, calcium and P levels used, as well as the presence of maize, coccidiostat and fat in the diet. Each of these factors can influence the response achieved and would alter the matrix assigned to the phytase from any one trial.
The best way to solve this problem is to increase the targeted performance by 1.7 x Standard Error (i.e., include 90 percent confidence limits). This results in the target for P replacement being achieved more than 90 percent of the time. Thus the security of the matrix is greatly increased, and the likelihood of a drop in animal performance is substantially reduced.
As market economics continue to put pressure on P levels in diets, the robustness of claimed phytase matrices will be tested more than ever. As a result, including a built-in safety margin to matrix derivation becomes more and more warranted. Feed producers need to consider the safety margins placed on phytase matrices so as to make true comparisons between products and evaluate the true cost savings associated with a given phytase.